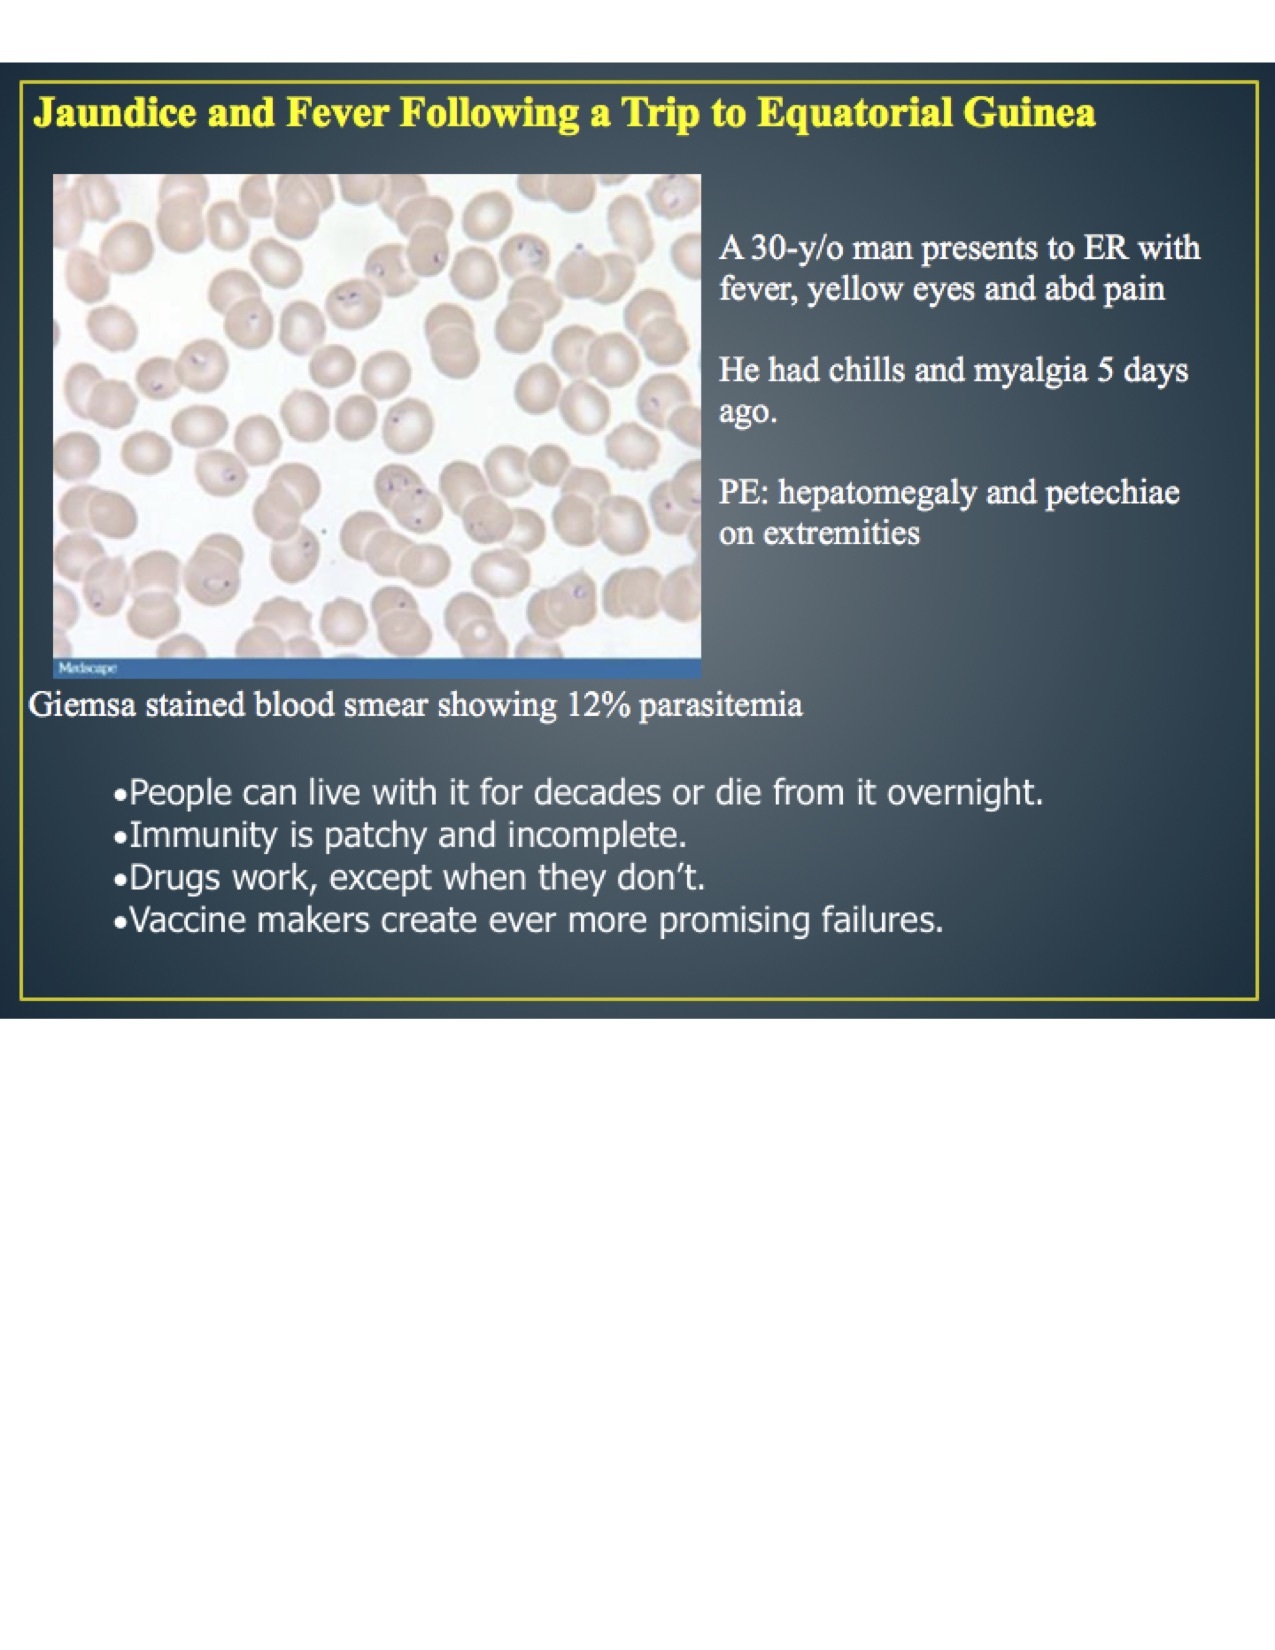

What is icterus?
jaundice
Life cycle of malaria? (3)
- upon mosquito bite, gametocytes fuse and sporozoites develop
- sporozoites enter lymph vessel to lymph nodes as well as capillaries
- from capillaries, they enter liver cells
- liver cells rupture and release merozites
- RBC are penetrated by merozites
- asexual reproduction
- development into gametocytes
- uptake in blood during mosquito meal

How many times does a mosquito bite? why?
- twice
- once to infect you
- once to feed off you
The clinical outcome of malarial infection in a patient depends on what?
- convergence of many parasite, host, geographic, and social factors
- this may result in a range of possible outcomes, from asymptomatic infection to severe disease and death
Pathogenesis of malaria? (4)
pic

Evasion of immune mechanism by Plasmodia?
- genome diversity
- cytoadherence, intraerythrotic sequestration, rosetting and knob formation
- switching “on” and “off” genes
How many countries are now malaria free? how many still have transmission?
- free: 109
- still transmit: 99
- proportion of worlds population who live in malaria endemic regions has decreased from 70% to 50%
When is fever produced during the malaria life cycle?
-when the schizonts mature at 48 hour intervals
Woman with seizures following fever case? (10)
pic

Man with jaundice and fever case? (11)
pic
Immunity for malaria?
- people can live with it for decades or die from it overnight
- immunity is patchy and incomplete
- drugs work, except when they don’t
- vaccine makers create ever more promising failures
Male refugee case? (12)
pic

What is the gold standard for determining malaria?
-thick and thin peripheral blood smears
Plasmodia are?
intra-erythrotic
What is the most lethal form of malaria?
P. falciparum
What is the most common form and may cause relapse?
P. vivax
What are the different ways of diagnosing a malarial infection? (16)
- direct visualization of parasites
- detection of parasite biomarkers
- detection of host biomarkers

What are some signs and symptoms of malaria?
- fever
- severe anemia
- nephrotic syndrome
- splenomegaly
How does one get cerebral malaria?
-malaria parasites are sequestered in small blood vessels
Man with fever, chills case? (17)
pic

When is malaria considered severe?
when more than 5% of RBCs are parasitized
Signs and symptoms of severe malaria?
- jaundice
- pulmonary edema
- gingival bleeding
- ARDS
Why could a relapse occur?
- due to the formation of hypnozoites in liver
- symptoms are triggered under stress
- types: P. vivax, P. ovale
What is the major public health intervention in malaria?
doors and window screens



